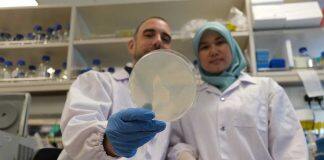
Stress response in cells key to slow down ageing: Study

About Singapore Education News, Study in Singapore, Education in Singapore, Singapore University, University News, University Ranking, Study Abroad, Online Education, Education News, Education Fairs, Job Opportunities, Graduate Program, Undergraduate Programs, Admissions, etc…
Tag: Singapore News
NUS College celebrates official launch
NUS College, Singapore’s first honours college, celebrated its official launch at the National University of Singapore (NUS).
FASS hosts over 300 students from the region at Global Youth...
More than 300 students from secondary schools and pre-university institutions discussed global developments and issues at the Global Youth Leaders’ Summit (GYLS) hosted by the NUS Faculty of Arts and Social Sciences (FASS)
Chatbots can help treat symptoms in people with depression
Clinician scientists from NTU Singapore have found that mental health chatbots are able to effectively engage people with depression in empathetic conversations and assist in the treatment of their symptoms.
NUS historian Asst Prof Jack Chia elected Fellow of the Royal...
NUS Faculty of Arts and Social Sciences (FASS) historian Assistant Professor Jack Chia has been elected a Fellow of the Royal Historical Society (RHS) “in recognition of his contribution to historical scholarship”.
Building a regional marine research nexus centred in Singapore
As Singapore’s marine science community celebrates 20 years of prolific research on St John’s Island, the St John’s Island National Marine Laboratory gears up to play a larger regional role in marine science.
Stress response in cells key to slow down ageing: Study
NTU Singapore scientists have found that a stress response in cells, when ‘switched on’ at a post-reproductive age, could be the key to slow down ageing and promote longevity.
Standard for AI security in Singapore launched
Answering the call to protect the integrity of AI programmes and create trust in AI solutions, a team of NTU Singapore researchers and AI industry leaders has launched a new standard on AI security.
NUS University Professor Tan Chorh Chuan among three top recipients at...
NUS University Professor Tan Chorh Chuan, along with Mr Gopinath Pillai, Senior Advisor to the NUS Institute of South Asian Studies, and Mr Lee Tzu Yang, a member of the S R Nathan Fellowship Committee at the NUS Institute of Policy Studies...
More scholarships for NUS Law postgraduate students through S$1m gift from...
The National University of Singapore Faculty of Law (NUS Law), has received a gift of S$1 million from Tahir Foundation which will go towards providing more scholarships for their postgraduate students.
Bullfrog skin to leapfrog from lab bench to clinics for wound...
A new clinical-grade collagen made from discarded bullfrog skin is leapfrogging from the lab bench to clinics soon.